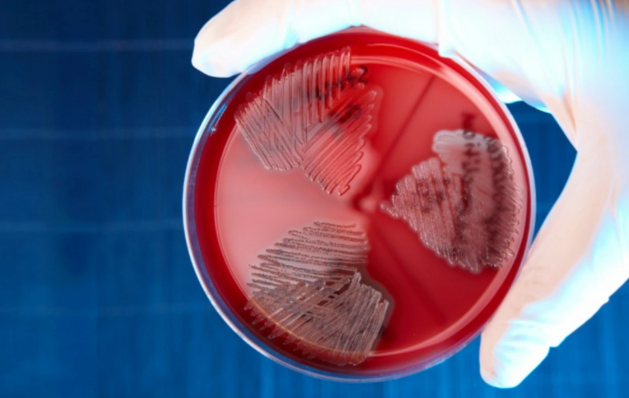
Honkonqda infeksiya partlayışı: Streptokokka yoluxanların sayı kəskin artıb

Honkonqda infeksiya partlayışı: Streptokokka yoluxanların sayı kəskin artıb
 Honkonqda insanlar üçün ölümcül olan B qrupu streptokokların (Streptococcus agalactiae) səbəb olduğu infeksiya partlayışı nəticəsində yoluxanların sayı 70-ə çatıb.
Honkonqda insanlar üçün ölümcül olan B qrupu streptokokların (Streptococcus agalactiae) səbəb olduğu infeksiya partlayışı nəticəsində yoluxanların sayı 70-ə çatıb.
Oxu.Az-ın şəhərin Səhiyyə Departamentinin nəzdindəki Sağlamlığın Qorunması Mərkəzinə istinadən verdiyi məlumata görə, üç xəstə vəfat edib.
Beş gün ərzində 36-95 yaş arası insanlarda 30 yeni xəstəlik halı qeydə alınıb. Xəstələrin əksəriyyətində sepsis və oynaq absesi müşahidə olunur.
Hazırda 45 xəstə tibb müəssisələrində stabil vəziyyətdə, üç nəfər ağır vəziyyətdə müalicə alır. Daha 19 nəfər xəstəxanalardan evə buraxılıb, üç nəfər vəfat edib.
Epidemioloqlar hesab edirlər ki, infeksiyanın yayılma mənbəyi şirin su balıqlarıdır. Sakinlər və turistlərdən xahiş olunur ki, onları saşimi və digər çiy və ya yarımçiy şəklində verilən yeməklərdə istifadə etməsinlər. Bundan əlavə, həkimlər bazarlara gedərkən ehtiyatlı olmağı və balığı yalnız qoruyucu əlcəklərlə təmizləməyi tövsiyə edirlər.
Sonxeber.az
 Telegramda izləyin
Telegramda izləyin
Dünyada Baxılıb: 493 Tarix: 21 sentyabr 2024
Şikayətiniz varsa Whatsapp: 077 7125666
Facebookda Paylaş
İran ABŞ-yə yeni nüvə təklifi verdi
İran ABŞ ilə aparılan dolayı danışıqlar çərçivəsində uranın 3.6%-dən yuxarı zənginləşdirilməsinin 10 il müddətinə dayandırılması təşəbbüsü ilə çıxış edib. xəbər verir ki, bu barədə "Al Hadath" mənbələrə istinadən məlumat yayıb. Məlumata görə, İran uranın 20%-dən yuxarı zənginləşdirilmiş hissəsin
24 mayPentaqon rəhbəri hərbçilərin sayını artırmağı planlaşdırır
ABŞ, ordusundakı hərbçilərin sayını 2027-ci ilə qədər artırmağı planlaşdırır. "Report" xəbər verir ki, bu barədə Pentaqon rəhbəri Pit Heqset bildirib. "Gələn il ordunun sayını artırdığımız zaman daha da böyük olacaq", - deyə o bildirib. Pentaqon rəhbəri əlavə edib ki, ABŞ ordusu 2026-c
24 mayPakistanda qatar partladıldı: 24 ölü, 50-dən çox yaralı
Pakistanın Kvetta şəhərində (Bəlucistan əyaləti) qatarın partladılması nəticəsində həlak olanların sayı 24 nəfərə çatıb, 50-dən çox insan isə xəsarət alıb. -ın məlumatına görə, bu barədə "Agence France-Presse" agentliyi yerli yüksəkvəzifəli məmura istinadən xəbər verir. "Qatar Kvettada
24 mayPaşinyan Axalkalaki-Qars dəmir yolunun fəaliyyətə başladığını bildirib
Ermənistanın baş naziri Nikol Paşinyan Axalkalaki-Qars dəmir yolunun fəaliyyətə başladığını bildirib. -ın məlumatına görə, erməni baş nazir bu barədə "Facebook" səhifəsində yazıb. "Axalkalaki-Qars dəmir yolunun, eləcə də Azərbaycanın dəmir yolunun bundan sonra Ermənistana ixrac və idxa
24 mayTramp Si Cinpinlə görüşündə Yaponiyanın Baş nazirini müdafiə edib
ABŞ Prezidenti Donald Tramp Çin Xalq Respublikasının Sədri Si Cinpinlə danışıqlar zamanı Çin lideri onu tənqid edərkən Yaponiyanın Baş naziri Sanae Takaiçini dəstəkləyib. "Report" xəbər verir ki, bu barədə Yaponiyanın "Yomiuri Shimbun" qəzeti hökumət mənbələrinə istinadən yazıb. Nəşri
24 mayQurban kəsimi rəsmən qadağan edildi - Bu ölkədə
Qurban bayramına sayılı günlər qalmış bəzi ölkələrdə dini qaydalara uyğun qurban kəsiminə tətbiq edilən məhdudiyyətlər yenidən gündəmə gəlib. -a istinadən xəbər verir ki, heyvan rifahı qanunları, ictimai asayiş və iqtisadi səbəblərlə müxtəlif tətbiqlərin həyata keçirildiyi bəzi ölkələrdə qurban kəsim
23 mayABŞ ordusunda hərbçilərin sayını artırır
ABŞ 2027-ci ildə silahlı qüvvələrinin şəxsi heyətini daha da artırmağı planlaşdırır. "RIA Novosti"yə istinadən xəbər verir ki, bu barədə ölkənin müdafiə naziri Pit Heqset açıqlama verib. O bildirib ki, hazırda ABŞ ordusunda təxminən 1.8 milyon hərbçi xidmət edir və qarşıdakı dövrdə bu rəqəmi
24 may Honkonqda insanlar üçün ölümcül olan B qrupu streptokokların (Streptococcus agalactiae) səbəb olduğu infeksiya partlayışı nəticəsində yoluxanların sayı 70-ə çatıb.
Honkonqda insanlar üçün ölümcül olan B qrupu streptokokların (Streptococcus agalactiae) səbəb olduğu infeksiya partlayışı nəticəsində yoluxanların sayı 70-ə çatıb. Telegramda izləyin
Telegramda izləyin












 Ev almaq istəyənlərə pis xəbər...
Ev almaq istəyənlərə pis xəbər... Sakinlərin NƏZƏRİNƏ: Bəzi ərazilərdə qaz olmayacaq
Sakinlərin NƏZƏRİNƏ: Bəzi ərazilərdə qaz olmayacaq Hava kəskin dəyişir - Bu tarixədək GÜCLÜ KÜLƏK XƏBƏRDARLIĞI
Hava kəskin dəyişir - Bu tarixədək GÜCLÜ KÜLƏK XƏBƏRDARLIĞI ABŞ və İran arasındakı sazişin təfərrüatı açıqlandı
ABŞ və İran arasındakı sazişin təfərrüatı açıqlandı İran polisindən Azərbaycanın Təbrizdəki konsulunun həlak olduğu qəza ilə bağlı AÇIQLAMA
İran polisindən Azərbaycanın Təbrizdəki konsulunun həlak olduğu qəza ilə bağlı AÇIQLAMA Bakıda nəqliyyat inqilabı: Gənclər tıxaclara qalib gəlirlər
Bakıda nəqliyyat inqilabı: Gənclər tıxaclara qalib gəlirlər Sabah hava yağıntılı olacaq
Sabah hava yağıntılı olacaq Pomidoru iri və bol yetişdirməyin SİRRİ - bu mətbəx tullantısını zibilliyə atmayın
Pomidoru iri və bol yetişdirməyin SİRRİ - bu mətbəx tullantısını zibilliyə atmayın Azərbaycanda müğənni qəfil vəfat etdi (FOTO)
Azərbaycanda müğənni qəfil vəfat etdi (FOTO) Müəllimini güllələyən şagirdin ittihamı ağırlaşdırıldı - Atası da dindirilib
Müəllimini güllələyən şagirdin ittihamı ağırlaşdırıldı - Atası da dindirilib Daha bir məşhur universitet TƏMİR OLUNACAQ
Daha bir məşhur universitet TƏMİR OLUNACAQ Vətən Müharibəsi Qəhrəmanı yüksək vəzifəyə - Təyin edildi
Vətən Müharibəsi Qəhrəmanı yüksək vəzifəyə - Təyin edildi Bakıda ər-arvad qətlə yetirildi
Bakıda ər-arvad qətlə yetirildi Paşinyan Baş nazir vəzifəsindən istefa verməsi üçün şərtini açıqlayıb
Paşinyan Baş nazir vəzifəsindən istefa verməsi üçün şərtini açıqlayıb Sərxoş sürücü ona yazılan cəriməni bəyənmədi: "Bu azdır" - VİDEO
Sərxoş sürücü ona yazılan cəriməni bəyənmədi: "Bu azdır" - VİDEO